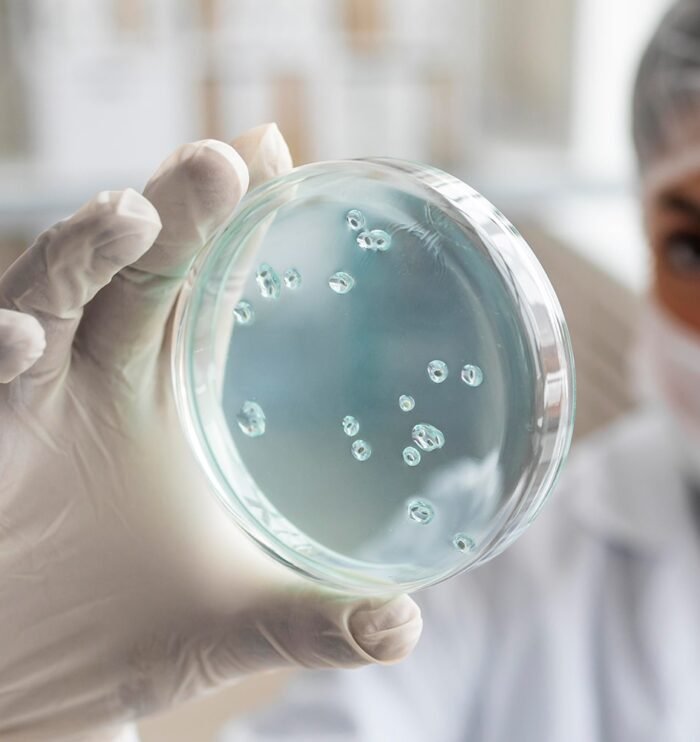

Laboratoire d'analyses biologique et médicale Zoubir
Prise de Sang -
Prélèvement à Domicile
prev
next
Better For You
Laboratoire Zoubir: Votre partenaire de confiance pour des analyses médicales à Casablanca.
Bienvenue à Laboratoire Zoubir, votre laboratoire d’analyses médicales de pointe à Casablanca! Nous sommes dévoués à fournir des services de diagnostic précis et fiables pour soutenir votre bien-être.
Nous avons établi une solide réputation d’excellence en offrant une large gamme d’analyses médicales et en garantissant des résultats rapides et précis.
Analyses Médicales Couvrant vos Besoins à Casablanca:
Notre gamme complète de services:
Pathology
Bilan hépatique
Pathology
Bilan rénal
Biochemistry
Bilan thyroïdien
Biochemistry
Bilan lipidique
Laboratory
Dépistage de drogues
Laboratory
Tests vétérinaires
Biosafety
Dépistage de l’anémie
Biosafety
Dépistage génétique
Oncology
Tests COVID-19
Oncology
Microbiologie à Casablanca
Clinical Research
Bilan d’infection
Clinical Research
Dosage hormonal
Better For You
Analyses Médicales Couvrant vos Besoins à Casablanca :
Laboratoire Zoubir propose une large gamme d’analyses médicales pour répondre à vos besoins de santé spécifiques, notamment:
- Bilans sanguins complets: Évaluez votre état de santé général.
- Analyses spécialisées: Dépistage de maladies, tests hormonaux, analyses microbiologiques, etc.
- Analyses de routine: Analyses pour surveiller des conditions préexistantes.
À propos de nous
Notre laboratoire opte pour une approche médicale et scientifique !
Optez pour une approche médicale et scientifique dans un laboratoire d’analyses médicales garantit la précision, la fiabilité et la conformité aux normes de qualité les plus élevées, contribuant ainsi à l’amélioration des soins de santé.
100
%
Fiabilité des résultats
42